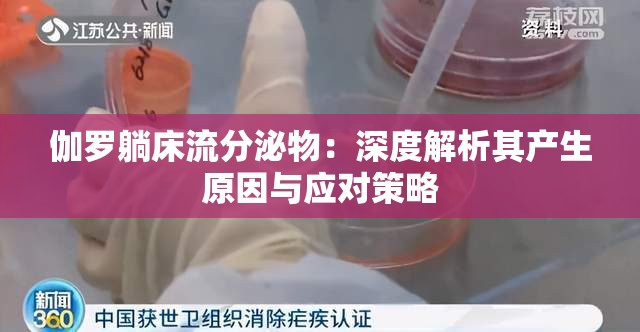
伽罗躺床流分泌物：深度解析其产生原因与应对策略

在这个纷繁复杂的世界里,总有一些独特而令人惊叹的存在,能瞬间吸引人们的目光。而乌克兰美女,无疑就是这样一群散发着独特魅力的存在。她们那深邃的眼眸、精致的面庞以及婀娜的身姿,早已成为无数人心中的梦幻图景。而当“乌克兰美女深喉口爆”这样极具诱惑性的词汇组合在一起时,更是引发了无尽的遐想与好奇。
乌克兰,这片广袤...
伽罗躺床流分泌物是一种较为常见但容易被忽视的现象。要深入了解这一现象,首先需要明确什么是“伽罗躺床流分泌物”。简单来说,它指的是在特定情境下,人体出现的非正常的分泌物流出情况。
产生伽罗躺床流分泌物的原因多种多样。其中,生理因素占据了重要的地位。例如,内分泌失调可能导致激素水平失衡,进而影响身体的正常分泌功...
文章主要介绍了十大免费行情网站免费版本,这些网站为投资者提供了精准的投资信息服务。以下是这些网站的介绍:
1. 东方财富网:提供全球财经新闻、股票行情、基金、外汇等多个领域的实时行情和数据,同时还提供财经新闻、研究报告、投资策略等内容。
2. 雪球:提供股票、基金、期货等多个市场的行情和数据,同时还提供财...
在当今数字化的时代,人们对于视觉体验的追求愈发强烈。爱爱动态图壁纸作为一种独特的存在,以其精美绝伦的画面和强烈的视觉冲击力,吸引了众多人的目光。
爱爱动态图壁纸往往具有极其细腻的画面质感。无论是细腻的肌肤纹理、动人的表情变化,还是绚丽多彩的背景场景,都能够通过动态的形式展现得淋漓尽致。每一个细节都被精心雕琢...
在当今竞争激烈的保险市场中,保险公司女推销员以其独特的专业素养和热忱的服务态度,成为了行业中的一道亮丽风景线。她们用心服务每一位客户,不仅为客户提供了可靠的保障,还传递了温暖和信任。
专业是保险公司女推销员的立身之本。她们深入了解保险产品的各个细节,包括保险条款、理赔流程、风险评估等。通过不断的学习和培训,...
在遥远的时空深处,存在着一个神秘而奇幻的世界。这里云雾缭绕,山峦起伏,奇异的生物四处穿梭,仿佛进入了一个只有想象才能抵达的境地。
那片广袤的森林,树木高大而茂密,阳光透过枝叶的缝隙洒下,形成一片片斑驳的光影。林间弥漫着淡淡的雾气,仿佛给整个森林披上了一层神秘的面纱。在森林的深处,隐藏着一座古老的城堡,城堡的...
在当今竞争激烈的商业世界中,MBA(工商管理硕士)已经成为许多人追求职业发展和提升个人能力的热门选择。对于那些尚未深入了解 MBA 的人来说,这个领域可能充满了神秘和未知。那么,让我们一同踏上探索 MBA 奥秘的旅程。
MBA 课程的核心价值在于为学生提供全面的商业知识和管理技能。它涵盖了诸如市场营销、财务...
在当今数字化的时代,互联网成为了人们获取信息和娱乐的主要渠道。而在这个广阔的网络世界中,有一个备受关注的领域——品色堂日韩。这个名字或许对于一些人来说还比较陌生,但它却蕴含着丰富的内容和独特的魅力。今天,让我们一同揭开品色堂日韩的神秘面纱,探索其中的精彩之处🎭。
品色堂日韩的定义与起源
品色堂日韩是一个涵...
在欧美音乐的广阔领域中,一曲、二曲和三曲常常展现出显著的差异,这些差异不仅体现在旋律和歌词上,更深入到文化内涵的层面,共同塑造了丰富多彩的音乐世界。
旋律方面,一曲可能具有简洁而直接的特点,通常以易于记忆和传唱的旋律线条吸引听众。它的节奏可能较为明快,使人在聆听时能够迅速跟上节奏并产生共鸣。例如一些流行的欧...
今天,家里格外安静,父母都出门去了,而姐姐恰好也不在家。我独自待在家里,开始了一场别样的奇妙经历。
清晨的阳光透过窗户洒进来,唤醒了还沉浸在睡梦中的我。我伸了个懒腰,慢悠悠地从床上爬起来,感受着这难得的自由时光。家里没有了姐姐的唠叨和管束,一切都变得那么新奇有趣。
我先是来到客厅,打开电视,尽情地享受着各...
在美妆的广袤天地里,总有一些产品如同璀璨星辰,一经登场便吸引无数目光。YSL 水蜜桃 86 高清,就是这样一颗耀眼的明星。今天,就让我们一同深入探索它的神秘魅力,分享那些令人心动的使用心得。
YSL 水蜜桃 86 高清,光是名字就充满了梦幻与诱惑。它的外观设计延续了 YSL 一贯的高级感与时尚风格。精致的瓶...
在互联网的浩瀚海洋中,域名犹如一个个独特的标识,承载着网站的身份与意义。对于网站运营者、网络爱好者以及从事相关领域工作的人来说,快速准确地了解域名信息至关重要。而 tai9vip 域名查询工具正是这样一款能够满足这一需求的实用利器。
tai9vip 域名查询工具具备诸多显著的优势。它提供了极为便捷的查询方式...
俄罗斯人和 zoom 人是两个具有不同文化背景和生活方式的群体。尽管他们都生活在现代社会中,但他们之间存在着一些明显的区别。
文化背景
俄罗斯人有着悠久的历史和丰富的文化传统。他们深受东正教、斯拉夫文化和苏联时期的影响。俄罗斯文化强调家庭、友谊和社交关系的重要性,人们通常更加注重人际关系和社交活动。
Z...
# 用文字传递温暖与责任
在当今社会,信息的传播速度之快、范围之广超乎想象。而在这信息的海洋中,文字始终占据着重要的地位。作为一名责任编辑,肩负着用文字传递温暖与责任的使命,就如同在黑暗中点亮一盏明灯,为读者指引方向。
37 岁,对于很多人来说,或许是一个事业稳定、生活安逸的阶段。但对于那些怀揣着理想和热...
在城市的喧嚣与繁华背后,隐藏着许多不为人知的角落和故事。澡堂,这个看似平凡却又充满独特韵味的地方,也上演着一幕幕别样的人生戏剧。
小李是一名普通的搓澡工,他身材高大健壮,有着一双粗糙而有力的手。每天清晨,他便早早地来到澡堂,开始一天忙碌而充实的工作。他熟练地为顾客搓去身上的污垢,让他们在舒适中放松身心。小李...
在这个数字化的时代,我们生活在一个信息透明的世界里。有时候我们渴望摆脱这种束缚,追求一些独特而神秘的体验。这就是为什么巧妙地利用隐私位置可以成为一种获取独特体验的绝佳方式。我将分享一些创意和实用的方法,帮助你探索隐私位置,开启与众不同的旅程。
打破常规,寻找隐藏的宝藏
有时候,最令人惊喜的体验往往隐藏在我...
在这个纷繁复杂的世界里,我们总是在不断追寻着那些能够带给我们独特体验和极致快感的事物。而当提及“九一爽爽爽”时,仿佛打开了一扇通往别样奇妙世界的大门,引领着我们去领略那与众不同的爽快感。
九一爽爽爽,它不仅仅是一个简单的词汇组合,更是一种蕴含着无限魅力和活力的象征。它所代表的,是一种能够瞬间点燃内心激情、让...
中国新疆,这片广袤而神奇的土地,宛如一颗镶嵌在欧亚大陆上的璀璨明珠,承载着数千年的历史文化与无与伦比的自然瑰宝,等待着无数人前来探索与发现。
新疆的文化,是中华民族多元文化的重要组成部分。这里有着悠久而灿烂的古代文明,古老的丝绸之路曾在这里交汇,东西方的文化在这里相互交融、相互影响。从古老的龟兹石窟到神秘的...
在现代工业的纷繁领域中,金属加工犹如一颗璀璨的明珠,散发着独特而耀眼的光芒。而仙踪林直接入口,凭借其在金属加工领域所展现出的精湛工艺与无与伦比的独特魅力,成为了行业内的翘楚。
仙踪林直接入口对于金属加工工艺的执着追求,铸就了其非凡的品质。从选材开始,他们精心挑选最优质的金属原材料,确保每一块金属都具备卓越的...
欧美,那片充满神秘与魅力的土地,一直以来都吸引着无数人去探寻其独特的风情。而通过欧美激情呦交这样一种方式,更是能够带来别样的、深入体验异国文化的奇妙经历。
欧美文化有着其独特的价值观和生活方式。在欧美激情呦交的过程中,我们能够亲身感受到他们开放、自由的性观念。这种观念并非是简单的放纵,而是在尊重彼此意愿和边...